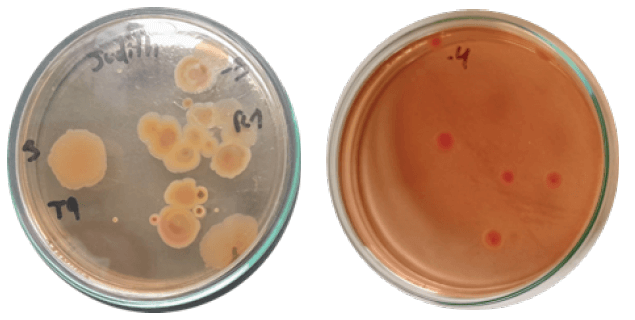
Figura 1. Detección de UFC, de Salmonella spp. en carne bovina

,
Diego Armando Tuárez García1
,
Diego Armando Tuárez García1  ,
Judith Elizabeth Castro Aguirre2
,
Judith Elizabeth Castro Aguirre2  ,
,  ,
Esperanza Del Pilar Varela Bravo2
,
Esperanza Del Pilar Varela Bravo2  ,
Evelyn Janina García Arellano2
,
Evelyn Janina García Arellano2  ,
,  ,
Sanyi Lorena Rodríguez Cevallos4
,
Sanyi Lorena Rodríguez Cevallos4 
Publicado: 15/02/2026
Introducción: La carne bovina es una fuente nutricional ampliamente consumida; sin embargo, puede actuar como vehículo de transmisión de bacterias patógenas como Salmonella spp., representando un riesgo sanitario relevante. En Ecuador, la vigilancia microbiológica en mercados locales aún presenta vacíos críticos. Objetivo: Detectar, caracterizar e inhibir el crecimiento de Salmonella spp. en carne bovina expendida en el mercado central del cantón El Empalme (Ecuador), evaluando la eficacia antimicrobiana de extractos cítricos naturales. Materiales y métodos: Se realizó un muestreo aleatorio simple de carne bovina comercializada. El aislamiento y caracterización de Salmonella spp. se efectuaron mediante técnicas microbiológicas y bioquímicas. Se aplicó un diseño completamente al azar con estructura bifactorial AxB, evaluando tres extractos (limón, naranja, mandarina) en tres concentraciones (100 %, 75 %, 50 %). Se analizó la capacidad inhibitoria mediante pruebas de antibiograma y análisis estadístico (ANOVA y Tukey, p ≤ 0.05). Resultados: Se confirmó la presencia de Salmonella spp. en todas las muestras. Las cepas aisladas presentaron características morfológicas y bioquímicas homogéneas. Los extractos de limón al 100 % y 75 % mostraron la mayor inhibición bacteriana, seguidos del extracto de naranja al 100 %. Las concentraciones del 50 % y el extracto de mandarina no evidenciaron efectos significativos. Conclusiones: La presencia de Salmonella spp. en carne bovina comercializada en El Empalme representa un riesgo para la salud pública. Los extractos de limón y naranja, particularmente en altas concentraciones, exhiben un prometedor potencial como agentes antimicrobianos naturales, siendo una alternativa viable para mejorar la inocuidad alimentaria sin recurrir a compuestos sintéticos. Arch Latinoam Nutr 2026; 76(1): 12-22.
Palabras clave: Antimicrobiano, Salmonella contaminación, inocuidad alimentaria, patógeno, carne bovina.
Introduction: Beef is a widely consumed food source; however, it can serve as a reservoir for pathogenic bacteria such as Salmonella spp., posing a major public health concern. In Ecuador, microbiological monitoring in local markets remains insufficient. Objective: To detect, characterize, and inhibit the growth of Salmonella spp. in beef sold at the central market of El Empalme (Ecuador), while evaluating the antimicrobial effect of natural citrus extracts. Materials y methods: A simple random sampling method was employed to collect beef samples. Isolation and identification of Salmonella spp. were conducted using standard microbiological and biochemical assays. A completely randomized design with a bifactorial structure (A×B) was applied, where factor A included three citrus extracts (lemon, orange, mandarin) and factor B included three concentrations (100 %, 75 %, 50 %). Inhibitory activity was assessed via antibiogram testing and statistical analysis (ANOVA and Tukey’s test, p ≤ 0.05). Results: Salmonella spp. was detected in all samples. The isolated strains shared similar morphological and biochemical features. Lemon extracts at 100 % and 75 % concentrations exhibited the strongest antimicrobial activity, followed by orange extract at 100 %. In contrast, the mandarin extract and all treatments at 50 % concentration showed no significant inhibitory effect. Conclusions: The detection of Salmonella spp. in beef from El Empalme poses a significant health risk. Lemon and orange extracts, particularly at higher concentrations, demonstrate strong antimicrobial potential, offering a viable natural alternative to synthetic preservatives for enhancing beef safety. Arch Latinoam Nutr 2026; 76(1): 12-22.
Keywords: Antimicrobial, Salmonella contamination, food safety, pathogen, beef.
https://doi.org/10.37527/2026.76.1.002
Autor para la correspondencia: Luis Humberto Vásquez Cortez, e-mail: [email protected]
La carne de bovino es uno de los alimentos con un consumo frecuente y de valor nutricional alto, sin embargo, su inocuidad puede verse afectada por contaminación microbiana a lo largo de la cadena, desde el faenamiento hasta su comercialización y la manipulación en el punto de comercialización. En contexto de comercialización tradicional, la variabilidad en la práctica de higiene incrementa el riesgo de contaminación y hace necesario fortalecer medidas de control aplicables en condiciones reales (1).
Entre los patógenos asociados a alimentos de origen animal, Salmonella spp. destaca por su importancia en salud pública y por su capacidad de causar salmonelosis a través del consumo de alimentos contaminados. Esta bacteria puede llegar al consumidor por fallas en higiene, contaminación cruzada y conservación inadecuada, por lo que constituye un objetivo prioritario en acciones de inocuidad alimentaria (2).
En Ecuador y otros países de la región se han descrito hallazgos de Salmonella spp. en matrices cárnicas comercializadas, lo que evidencia que el riesgo puede estar presente en mercados y puntos de venta. Estos antecedentes sustentan la necesidad de investigaciones locales que caractericen la presencia del patógeno y permitan orientar medidas de prevención y control en la carne destinada al consumo humano (3).
Las infecciones transmitidas por alimentos continúan siendo un problema relevante, especialmente por su impacto en morbilidad y por los efectos que generan en población vulnerable. La salmonelosis puede producir cuadros gastrointestinales y, dependiendo del serotipo y del estado del paciente, evolucionar hacia manifestaciones más severas; por ello, la prevención se fundamenta en higiene, control sanitario y reducción del riesgo en alimentos (4).
En cara a esta problemática, ha incrementado el interés por estrategias naturales que actúen como barreras antimicrobianas complementarias, ya sea mediante aplicaciones directas, recubrimientos o combinaciones tecnológica. En particular se ha documentado el gran potencial de aceites esenciales y extractos naturales de origen vegetal como herramientas para el control microbiano, en especial de los patógenos, aunque su eficacia depende de la formulación y del tipo de alimento (5).
La evaluación de los cítricos como preservantes naturales se fundamenta en su composición bioactiva. Hallazgos recientes subrayan que los extractos de Citrus limon no solo inhiben el desarrollo de Salmonella spp., sino que ofrecen una ruta sostenible para la desinfección de productos alimenticios, validando su interés científico y comercial (6).
Además, en investigaciones sobre la carne de bovino se han evaluado extractos de cáscara de cítricos ricos en limoneno, demostrando una excelente actividad microbiana frete a microrganismo relevantes para la seguridad alimentaria incluyendo el Salmonella spp, lo que sugiere aplicabilidad tecnológica en productos cárnicos bajo condiciones controladas (7).En este contexto, la presente investigación tuvo como objetivo general caracterizar e inhibir el crecimiento de Salmonella spp. en carne bovina comercializada en el mercado del cantón El Empalme (Ecuador), evaluando el efecto inhibitorio de extractos de limón, naranja y mandarina a diferentes concentraciones, como alternativa práctica de control microbiológico (8).
Desde una perspectiva epidemiológica y microbiológica aplicada a la inocuidad alimentaria, Salmonella enterica es reconocida como uno de los principales patógenos zoonóticos asociados a enfermedades transmitidas por alimentos (ETA), particularmente vinculadas al consumo de carnes y productos cárnicos (9). Diversos estudios han evidenciado de forma consistente la presencia, diversidad genética y capacidad patogénica de Salmonella en matrices cárnicas destinadas al consumo humano, consolidando su relevancia como un problema prioritario de salud pública (10,11).
En este contexto, Lyu et al. caracterizaron genómicamente aislamientos de Salmonella enterica obtenidos de carnes comercializadas al por menor en Beijing, China, identificando una elevada diversidad de serotipos, así como la presencia de múltiples genes de virulencia y determinantes de resistencia antimicrobiana, lo que sugiere la circulación activa de cepas con alto potencial patogénico dentro de la cadena alimentaria (9).
De manera concordante, Ho-Palma et al. reportaron una alta prevalencia de Salmonella en carne de pollo y cerdo en Perú, identificando estos productos como uno de los principales contribuyentes a la carga nacional de ETA. El estudio destaca que la contaminación puede producirse en diferentes etapas de la cadena productiva, desde el sacrificio hasta la comercialización, y que las deficiencias en las prácticas higiénico-sanitarias incrementan significativamente el riesgo de infección en la población (10).
Asimismo, en Europa, Terentjeva et al. evaluaron la prevalencia y los perfiles de resistencia antimicrobiana de Salmonella en carnes y productos cárnicos en Letonia, evidenciando una presencia persistente del patógeno y la detección de cepas resistentes a antimicrobianos de uso común. Estos resultados representan un desafío adicional para el control microbiológico de los alimentos y el manejo clínico de la salmonelosis, reforzando el carácter global de esta problemática (11).
En conjunto, la evidencia científica disponible demuestra que Salmonella spp. continúa siendo un contaminante recurrente en carnes avícolas y porcinas, con elevada variabilidad genética y potencial patogénico, lo que justifica la necesidad de fortalecer los programas de vigilancia microbiológica y de implementar estrategias de control más eficaces a lo largo de la cadena agroalimentaria.
Diversos estudios han evidenciado que, ante la creciente preocupación por la contaminación de carnes con patógenos de importancia alimentaria como Salmonella spp., se ha intensificado la búsqueda de alternativas naturales para su control microbiológico. En este contexto, los compuestos derivados de cítricos, particularmente los aceites esenciales y extractos obtenidos de cáscaras de frutas cítricas, han demostrado un notable potencial antimicrobiano aplicado a matrices cárnicas.
Pittman et al. evaluaron la actividad de aceites esenciales cítricos sobre cortes de carne bovina inoculados con Salmonella spp., observando reducciones significativas en la carga bacteriana durante el almacenamiento refrigerado, lo que confirma su efectividad como agentes antimicrobianos naturales en productos cárnicos (12). Estos resultados sugieren que los aceites esenciales de cítricos pueden actuar como una barrera eficaz frente a la proliferación de patógenos, contribuyendo a mejorar la inocuidad de la carne.
Asimismo, Fisher y Phillips reportaron que los aceites esenciales derivados de cítricos, ricos en compuestos como limoneno y otros terpenos, presentan una elevada actividad inhibitoria frente a bacterias entéricas, incluyendo Salmonella, lo que respalda su aplicación potencial en sistemas de conservación de alimentos de origen animal (13). En conjunto, estos antecedentes evidencian que los cítricos constituyen una alternativa natural prometedora para reducir la contaminación bacteriana en carnes, alineándose con las tendencias actuales hacia el uso de conservantes naturales y tecnologías de preservación más seguras y sostenibles.
En términos clínicos, las manifestaciones causadas por Salmonella pueden variar en severidad, en función de la especie involucrada (14). Existen dos grupos principales: la Salmonella tifoidea, asociada con infecciones sistémicas más graves como la fiebre tifoidea; y la Salmonella no tifoidea, que suele provocar gastroenteritis aguda, caracterizada por síntomas gastrointestinales moderados o leves (15,16).
En este contexto, la presente investigación tuvo como objetivo general caracterizar e inhibir el crecimiento de Salmonella spp. en carne bovina comercializada en el mercado del cantón El Empalme (Ecuador), evaluando el efecto inhibitorio de extractos de limón, naranja y mandarina a diferentes concentraciones, como alternativa práctica de control microbiológico (8).
La investigación se desarrolló durante el segundo semestre del año 2024, específicamente entre los meses de julio y noviembre, bajo las condiciones climáticas del cantón El Empalme, provincia del Guayas, Ecuador. Esta zona presenta un clima tropical, con temperaturas medias anuales comprendidas entre 25 y 27 °C y una altitud aproximada de 74 m s. n. m., ubicada a 167 km de Guayaquil y 21 km de Quevedo.
En el desarrollo de esta investigación se empleó un diseño completamente al azar (DCA) con estructura bifactorial AxB. El factor A correspondió a los tipos de inhibidores naturales utilizados (extractos de limón, naranja y mandarina), mientras que el factor B estuvo constituido por los niveles de concentración aplicados (100 %, 75 % y 50 %). Se evaluaron un total de 9 tratamientos, cada uno con 3 repeticiones, un total de 27 objetos de estudio. Para establecer diferencias significativas entre las medias de los tratamientos se aplicó la prueba de comparación múltiple de Tukey, utilizando un nivel de significancia del 5 % (P ≤ 0,05).
El estudio se desarrolló bajo un diseño experimental estructurado en cuatro fases: (i) muestreo y transporte de muestras de carne bovina, (ii) aislamiento e identificación de Salmonella spp., (iii) preparación de los extractos cítricos y (iv) evaluación del efecto inhibitorio y análisis estadístico de los datos.
Para la recolección de datos se aplicó un diseño muestral probabilístico de tipo aleatorio simple, garantizando que cada unidad muestral de la población tuviese la misma probabilidad de ser seleccionada. La población de estudio estuvo constituida por muestras de carne bovina expendidas en distintos establecimientos del mercado municipal del cantón El Empalme.
El muestreo se realizó mediante un diseño probabilístico aleatorio simple. Se elaboró un listado de los establecimientos de expendio de carne bovina del mercado municipal del cantón El Empalme, a partir del cual se seleccionaron aleatoriamente cinco puestos de venta.
En cada establecimiento se recolectaron aproximadamente 100 g de carne bovina correspondiente al corte (lomo), por ser de consumo frecuente en el ámbito doméstico. La toma de muestra se efectuó con material estéril, garantizando condiciones asépticas durante la manipulación.
Se excluyeron muestras que presentaron signos visibles de deterioro, tales como cambios de color anormales, olor desagradable, textura viscosa o presencia de moho, con el fin de evitar sesgos asociados a procesos de descomposición avanzada.
El procedimiento de recolección de muestras se llevó a cabo asegurando que la carne no presentara alteraciones posteriores a su obtención, con el fin de evitar interferencias en la detección de Salmonella spp. (19). Para garantizar la integridad microbiológica de las muestras, se emplearon guantes estériles durante la manipulación del producto cárnico. Una vez recolectadas, las porciones fueron colocadas en bolsas estériles tipo Whirl-Pak, correctamente rotuladas, y luego almacenadas en una hielera portátil, lo cual permitió conservar las condiciones adecuadas de temperatura durante el traslado hasta el laboratorio de Microbiología de la Universidad Técnica Estatal de Quevedo.
Los frutos de limón, naranja y mandarina se seleccionaron en estado de madurez comercial, lavados con agua potable y desinfectados con una solución de hipoclorito de sodio a concentración 100 ppm durante 10 minutos. Posteriormente se retiró la cáscara y se obtuvo el jugo o el extracto por prensado, seguido de filtración a través de gasa estéril o papel de filtro para eliminar sólidos.
El extracto puro se consideró como concentración al 100% y se prepararon diluciones al 75% y 50% utilizando agua destilada estéril como diluyente, en condiciones asépticas. Los extractos se almacenaron en frascos estériles ámbar a 4 °C y se utilizaron en un plazo no mayor a 24 h.
El tratamiento control consistió en la aplicación exclusiva del diluyente (agua destilada estéril), sin adición de extracto cítrico, bajo las mismas condiciones experimentales que los tratamientos evaluados.
Cada una de las muestras (~100 g), fueron colocadas en bolsas estériles de tipo Whirl-Pak®, previamente rotuladas de manera individual y transportadas en una hielera portátil a 4 ± 1 °C. El tiempo que transcurrió entre la adquisición y el procedimiento en laboratorio no superó las 2 horas.
Los datos de los diámetros de halos de inhibición se analizaron mediante análisis de varianza (ANOVA) bifactorial A×B, utilizando el software estadístico InfoStat. Previo al análisis, se verificaron los supuestos de normalidad mediante la prueba de Shapiro-Wilk y la homogeneidad de varianzas con la prueba de Levene. Dado que se detectó interacción significativa entre los factores A (tipo de extracto) y B (concentración), los resultados se presentan únicamente para la interacción extracto × concentración (A×B). Las diferencias entre tratamientos se determinaron mediante la prueba de comparación múltiple de Tukey a un nivel de significancia de p ≤ 0,05.
El aislamiento presuntivo de Salmonella spp. se realizó siguiendo lineamientos generales del Bacteriological Analytical Manual (BAM) de la Food and Drug Administration (FDA). Las muestras fueron homogenizadas, sometidas a diluciones seriadas y sembradas en agar Salmonella–Shigella (SS), incubándose a 37 °C durante 24–36 h para la obtención de colonias presuntivas.
En la fase de preparación de las muestras, se realizó la maceración de un gramo de carne bovina en 9 mililitros de solución salina estéril (0,85%), obteniéndose la dilución 10-¹. Posteriormente, se prepararon diluciones decimales sucesivas (10-², 10-³, 10-⁴) para favorecer el aislamiento selectivo de Salmonella spp. Alícuotas de 0,1 mL de cada dilución se sembraron por el método de siembra en superficie en placas de Agar Xilosa-Lisina-Desoxicolato (XLD), medio recomendado para aislamiento diferencial de Salmonella spp., y en Agar Hektoen (HE) para confirmación. Las placas fueron incubadas a 37 °C durante 24 horas, permitiendo el desarrollo de colonias características. Las colonias compatibles con Salmonella spp. fueron contadas y los resultados se expresaron en Unidades Formadoras de Colonias por gramo de muestra (UFC/g).
De cada muestra de carne bovina se seleccionó al menos un aislamiento presuntivo de Salmonella spp. para su caracterización morfológica y bioquímica, así como para su posterior evaluación en los ensayos de inhibición.
El efecto inhibitorio de los extractos cítricos se evaluó mediante la técnica de difusión en agar. Las suspensiones bacterianas de Salmonella spp. se ajustaron a una turbidez equivalente a 0,5 de la escala de McFarland y se sembraron uniformemente sobre agar Mueller–Hinton. Posteriormente, se colocaron discos estériles impregnados con los extractos a las diferentes concentraciones evaluadas. Las placas se incubaron a 37 °C durante 24 h y el efecto inhibitorio se determinó mediante la medición del diámetro de los halos de inhibición (mm).
La identificación de Salmonella spp. se realizó mediante las pruebas de catalasa y tinción de Gram. En la prueba de catalasa, se añadió peróxido de hidrógeno al 3% a una muestra del cultivo, observándose la formación de burbujas gaseosas indicativa de positividad. Para la tinción de Gram, se siguió el procedimiento estándar: aplicación de cristal violeta, tratamiento con lugol como mordiente, decoloración con alcohol-acetona y tinción de contraste con safranina. Salmonella spp. fue identificada como una bacteria Gram negativa, confirmada por la adquisición de la coloración rojiza característica de la safranina.
La identificación morfológica incluyó la tinción de Gram, realizada mediante cristal violeta, lugol, decoloración con mezcla alcohol–acetona y tinción de contraste con safranina. Posteriormente, las colonias presuntivas fueron sometidas a pruebas bioquímicas convencionales, incluyendo agar Triple Sugar Iron (TSI), agar Lysine Iron Agar (LIA) y prueba de ureasa, para la identificación presuntiva de Salmonella spp.
La tinción de gran se realizó sobre las colonias presuntivas de Salmonella spp, previamente extendida en los portaobjetos. Dicho procedimiento incluyó la aplicación de cristal violeta como colorante primario, Lugol como mordiente, una etapa de decoloración con agua destilada y la aplicación de safranina como colorante de contraste. Posterior a eso las preparaciones fueron observadas en un microscopio óptico. La evaluación de respuesta tintorial, permitió clasificar a los microorganismos según la estructura presente en su pared celular. Los aislamientos analizados no retuvieron el cristal violeta y adquirieron una coloración con tonalidad rojiza. Este comportamiento permitió afirmar la naturaleza de bacilos Gran negativos, compatibles con el género Salmonella spp.
El protocolo de identificación comenzó con un ensayo de catalasa; la formación instantánea de oxígeno gaseoso nos indicó que la cepa era capaz de degradar el peróxido de hidrógeno. Con este indicio, profundizamos en la caracterización bioquímica utilizando medios TSI y LIA. Este paso permitió evaluar el comportamiento de la bacteria frente a carbohidratos y su capacidad para producir H₂S y gas. Finalmente, la prueba de descarboxilación de lisina terminó de perfilar el perfil metabólico característico de Salmonella spp.
Además de eso, la prueba de ureasa se llevó a cabo con la intención de discriminar Salmonella del resto de géneros de la familia Enterobacteriaceae que muestran capacidad ureásica positiva. Los aislamientos analizados dieron resultados negativos en esta prueba, lo que se corresponde con el perfil bioquímico esperado para Salmonella spp. De forma combinada, los resultados de las pruebas bioquímicas llevadas a cabo fueron conformes a la identificación fenotípica presumible del género Salmonella y le otorgan a su vez una buena base metodológica para su aplicación en los ensayos de inhibición bacteriana que se desarrollan en la presente investigación.
Se analizaron 5 muestras de carne bovina recolectadas en el mercado del cantón El Empalme. El recuento de Salmonella spp. en las muestras sin tratamiento osciló entre 2.4×10³ a 5.8×10³ UFC/g. Mediante técnicas microbiológicas estandarizadas de aislamiento en agar XLD y agar Hektoen, se confirmó la presencia de Salmonella spp. en el 100% (5/5) de las muestras analizadas, lo que evidencia una contaminación persistente del patógeno en la carne comercializada en este establecimiento, representando un riesgo sanitario crítico. Como se observa en la Figura 1, la cual proporciona una representación gráfica de las colonias de Salmonella observadas en el medio de cultivo selectivo utilizado. Este resultado recalca la importancia crítica de la vigilancia y el control de la calidad microbiológica de los productos cárnicos comercializados en la región, con implicaciones directas para la salud pública y la seguridad alimentaria de la comunidad.
Según lo reportado en la Tabla 1, todas las cepas analizadas (cepa 1 a cepa 5) presentaron similitudes notables en sus características morfológicas: morfología irregular, elevación plana, bordes enteros y coloración roja característica en Agar Salmonella-Shigella (SS), como se ilustra en la Figura 2. Estos rasgos confirman la homogeneidad morfológica típica de Salmonella spp. en medios selectivos.


La tinción de Gram reveló que todas las cinco cepas fueron bacilos Gram negativos, como se presenta en la Figura 3, manifestando coloración rojiza con safranina tras decoloración con alcohol-acetona. Esta característica es consistente con la pared celular delgada típica de bacterias Gram negativas del género Salmonella.

Los resultados de la prueba de catalasa indicaron reacción positiva en todas las cepas, confirmada por la liberación de burbujas de oxígeno tras la adición de peróxido de hidrógeno (H₂O₂ al 3%). Este hallazgo contribuye a la caracterización bioquímica presuntiva del grupo microbiano analizado.
Con base en los resultados obtenidos del análisis de varianza sobre la eficacia antimicrobiana de los tres extractos cítricos evaluados, y tal como se expone en la Figura 4, se identificaron diferencias estadísticamente significativas entre los tratamientos (p < 0,05). Los extractos de limón (Citrus limon) y naranja (Citrus sinensis) mostraron una inhibición significativamente superior en comparación con el extracto de mandarina (Citrus reticulata), el cual no presentó un efecto relevante sobre el crecimiento de Salmonella spp. (p < 0,01). La media general de inhibición registrada entre todos los tratamientos fue de 1,86.
Estos hallazgos respaldan el potencial uso de los extractos de limón y naranja como alternativas naturales con propiedades antimicrobianas para el control de Salmonella spp. en productos cárnicos bovinos, aportando así a la mejora de la inocuidad alimentaria mediante estrategias no químicas.

De acuerdo con el análisis de varianza reflejado en la Figura 5, se evidenció que las distintas concentraciones aplicadas en los tratamientos generaron diferencias significativas en la inhibición de Salmonella spp. La concentración del 100 % fue la más efectiva, alcanzando un valor medio de inhibición de 3,3 (letra A), con diferencias altamente significativas frente al resto de las concentraciones (p < 0,01). La concentración del 75 % obtuvo un promedio de 2,06 (letra B), mostrando una eficacia comparable, aunque sin alcanzar significancia estadística en relación con el tratamiento al 100 % (p > 0,05). En contraste, la concentración del 50 % presentó el menor efecto inhibitorio, con un valor promedio de 0,50, y no mostró diferencias significativas frente a las demás concentraciones evaluadas (p > 0,05).

El valor promedio de inhibición general entre todas las concentraciones fue de 1,86, lo que demuestra una respuesta biológica positiva de los microorganismos frente a los extractos cítricos, y sugiere que su eficacia está directamente relacionada con el nivel de concentración aplicado.
El análisis de varianza (Tabla 2) evidenció que tanto el tipo de inhibidor (Factor A) como la concentración aplicada (Factor B), así como su interacción, influyeron significativamente sobre el diámetro de inhibición frente a Salmonella spp. (p < 0,0001). El Factor B presentó el mayor efecto (SC = 98,88; F = 371,34), seguido por el tipo de inhibidor (SC = 18,94; F = 71,14). La interacción A×B también fue estadísticamente significativa (SC = 23,38; F = 43,90), lo que confirma que la eficacia antimicrobiana depende de la combinación específica de extracto y concentración.

Según la prueba de comparación múltiple de Tukey al 5 % de probabilidad (Figura 6), se identificaron diferencias estadísticamente significativas entre los tratamientos evaluados. Los tratamientos T1 (limón al 100 %) y T2 (limón al 75 %) alcanzaron los mayores diámetros de inhibición (3,19 mm y 3,12 mm, respectivamente), siendo agrupados en la misma letra estadística (A). Estos resultados confirman la alta capacidaddelextractodelimón, inclusoaconcentraciones inferiores al 100 %, para inhibir Salmonella spp. en carne bovina.

En un segundo nivel de eficacia se ubicaron T3 (naranja al 100 %) y T4 (mandarina al 100 %), con valores de 3,01 mm y 2,89 mm, respectivamente, clasificados en el grupo AB, lo que indica un efecto inhibidor relevante, aunque inferior al del limón. El tratamiento T5 (naranja al 75 %) obtuvo un valor intermedio de 2,56 mm, clasificado en el grupo B.
En contraste, los tratamientos T6 (mandarina al 75 %), T7 (limón al 50 %), T8 (naranja al 50 %) y T9 (mandarina al 50 %) no mostraron diferencias significativas entre sí (grupo C), confirmando una reducida actividad antimicrobiana a concentraciones más bajas. Estos resultados reafirman que la actividad inhibitoria de los extractos cítricos está directamente relacionada con la concentración y el tipo de fruto utilizado.
Los análisis microbiológicos realizados en las muestras de carne bovina provenientes del mercado del cantón El Empalme demostraron recuentos de Salmonella spp. entre 2,4 × 10³ y 5,8 × 10³ UFC/g en las muestras control (sin tratamiento), lo cual constituye un hallazgo de relevancia crítica desde la perspectiva de la inocuidad alimentaria. Estos niveles de contaminación superan los límites máximos permitidos según regulaciones internacionales de seguridad alimentaria. La aplicación de los extractos cítricos redujo significativamente estos recuentos, alcanzando reducciones del 98,5 % con el tratamiento de limón al 100 %, demostrando el potencial antimicrobiano de estos compuestos naturales (17,18).
Los análisis microbiológicos confirmaron la presencia de Salmonella spp. en el 100% (5/5) de las muestras de carne bovina del mercado de El Empalme, coincidiendo con tasas de contaminación reportadas en mercados similares de Ecuador (80-100%) por Quezada et al. (19) y en Colombia (95%) por Rodríguez et al. (20). Esta alta prevalencia evidencia fallas en la cadena de frío y manipulación, representando un riesgo significativo para la salud pública según datos de la OPS (21).
La identificación de Salmonella spp. en un alimento de alto consumo como la carne bovina no solo evidencia posibles deficiencias en las prácticas de manipulación, transporte y almacenamiento, sino que también pone de manifiesto la necesidad de reforzar las medidas preventivas en toda la cadena de suministro. La resistencia de esta bacteria a condiciones adversas y su capacidad de colonizar diferentes matrices alimentarias la convierten en un agente persistente y difícil de erradicar, lo que incrementa el riesgo de brotes si no se aplican protocolos de control y monitoreo adecuados. Asimismo, este hallazgo subraya la importancia de desarrollar estrategias complementarias que incluyan tanto la educación sanitaria de los manipuladores como la investigación de alternativas antimicrobianas naturales, orientadas a reducir la carga microbiana sin comprometer las características organolépticas del producto.
La caracterización morfológica reveló colonias uniformes (irregulares, elevación plana, bordes enteros, coloración roja en Agar SS), consistente con descripciones estándar de Salmonella spp. (22,23). Las pruebas presuntivas mostraron bacilos Gram negativos y catalasa positiva en todas las cepas, atributos típicos del género (17), aunque sin pruebas confirmatorias (TSI/LIA). Efecto inhibitorio de extractos cítricos sobre Salmonella spp. El extracto de limón (Citrus limon) mostró la mayor eficacia (diámetros de inhibición superiores), atribuible a su alto contenido de ácido cítrico (5-8%) y limoneno, según Fisher y Phillips (13). Este resultado difiere parcialmente de Picón et al. (24), quienes reportaron mayor efectividad de mandarina, pero coincide en la dependencia de la concentración (100% > 75% > 50%).
El extracto de naranja (Citrus sinensis) presentó inhibición intermedia, relacionada con sus ácidos orgánicos y flavonoides (18). Todos los extractos mostraron efecto dosis-dependiente significativo (p ≤0,05, Tukey), validando su potencial como conservantes naturales específicos contra Salmonella spp. en carne bovina (25,26).
Los extractos cítricos representan una alternativa sostenible para reducir Salmonella spp. en carne fresca, alineada con tendencias de biopreservación (1) y normativas ecuatorianas de inocuidad en el Ecuador.
Desde el análisis estadístico, se identificó que el extracto de naranja mostró una actividad inhibitoria relevante frente a bacterias Gram negativas, incluyendo Salmonella spp., efecto que se asocia a la presencia de ácidos orgánicos y aceites esenciales en su composición química. Este hallazgo concuerda con lo expuesto por Shiva y Calvo (18), quienes atribuyen dichas propiedades antimicrobianas a los componentes bioactivos del fruto. A pesar de que su nivel de inhibición fue inferior al del limón, su efectividad sigue siendo significativa, como también lo confirman Blas y Fernández (26).
La presencia de Salmonella spp. fue confirmada en el 100 % de las muestras analizadas (5/5) de carne bovina comercializada en el mercado del cantón El Empalme, evidenciando un riesgo sanitario potencial para la salud pública. Estos resultados indican posibles deficiencias en las condiciones higiénico-sanitarias a lo largo de la cadena de producción y comercialización, incluyendo etapas previas como el faenamiento, el procesamiento en plantas frigoríficas, el transporte y la manipulación en los puntos de expendio.
Los aislamientos obtenidos presentaron características morfológicas y bioquímicas compatibles con Salmonella spp., lo que permitió su identificación presuntiva mediante métodos microbiológicos convencionales. La detección del patógeno en todas las muestras analizadas confirma su circulación en la carne bovina expendida en el mercado evaluado.
Los extractos cítricos de limón y naranja mostraron actividad inhibitoria frente a Salmonella spp. en condiciones in vitro, especialmente a concentraciones del 100% y 75%, mientras que la concentración del 50 % no evidenció un efecto inhibitorio significativo. Estos resultados demuestran que la eficacia antimicrobiana de los extractos evaluados depende tanto del tipo de cítrico como de la concentración aplicada.
En conjunto, los hallazgos sugieren que los extractos cítricos, particularmente los de limón y naranja, podrían considerarse como una alternativa natural complementaria para la reducción de la carga bacteriana de Salmonella spp. en carne bovina. No obstante, su aplicación práctica debe ser evaluada bajo condiciones controladas y como parte de estrategias integrales de inocuidad alimentaria, sin sustituir las buenas prácticas de higiene y control sanitario a lo largo de la cadena cárnica.
Agradecemos profundamente a la Universidad Técnica Estatal de Quevedo a la Unidad de Posgrado, y a la Universidad Técnica de Babahoyo, por lograr ejecutar la presente investigación.
Los autores declaran no tener conflicto de interés en relación con el presente estudio.
Recibido: 07/08/2025
Aceptado: 29/01/2026